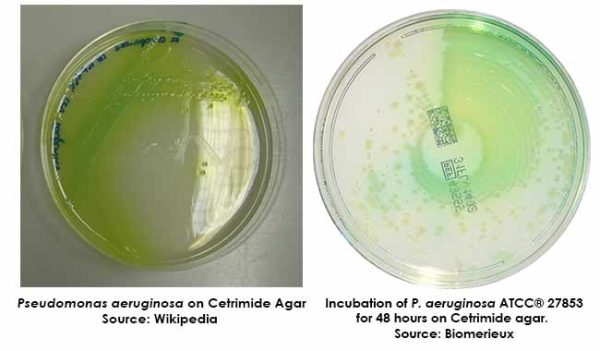
محیط کشت سترمايد آگار 500G كيولب

مشخصات محصول:
محیط کشت سترمایید آگار (CETERMIDE AGAR) کیولب یکی از انواع محیط کشت های مختلف آزمایشگاهی است که از این محیط برای جداسازی باکتری گرم منفی سودوموناس آئروژینوزا استفاده می شود. وجود استریمید یک عامل انتخابی برای محیط به شمار می رود.
ویژگی محیط کشت سترماید آگار (CETRIMIDE AGAR) کیولب
- یک محیط انتخابی – افتراقی
- وجود استریمید در حضور سودموناس باعث تغییر رنگ محیط به آبی –سبز می شود
کاربرد محیط کشت سترماید آگار (CETRIMIDE AGAR) کیولب
- به طور گسترده در آزمایش های دارویی، لوازم آرایشی و نمونه های بالینی کاربرد دارد
نظرات دوستان